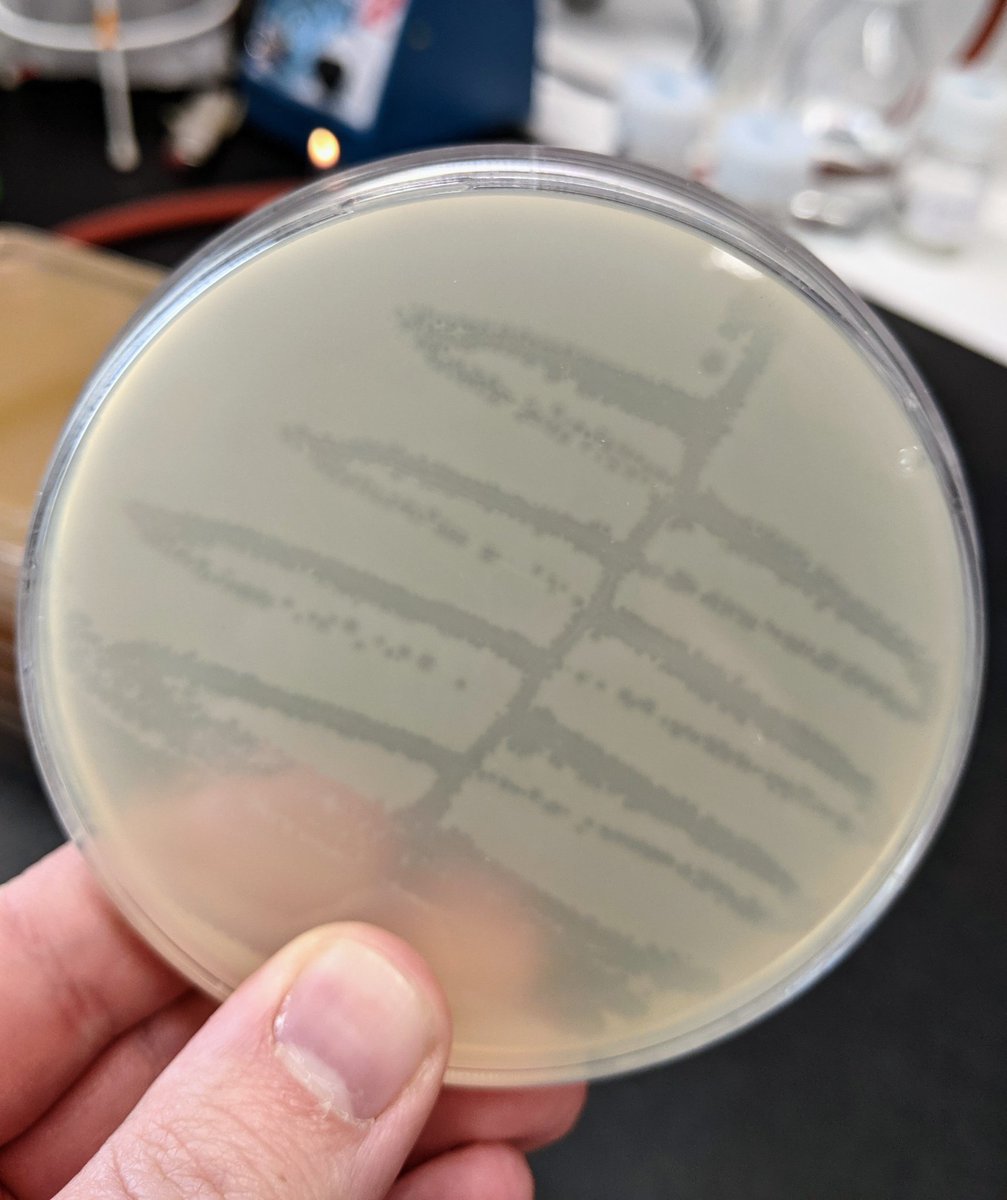
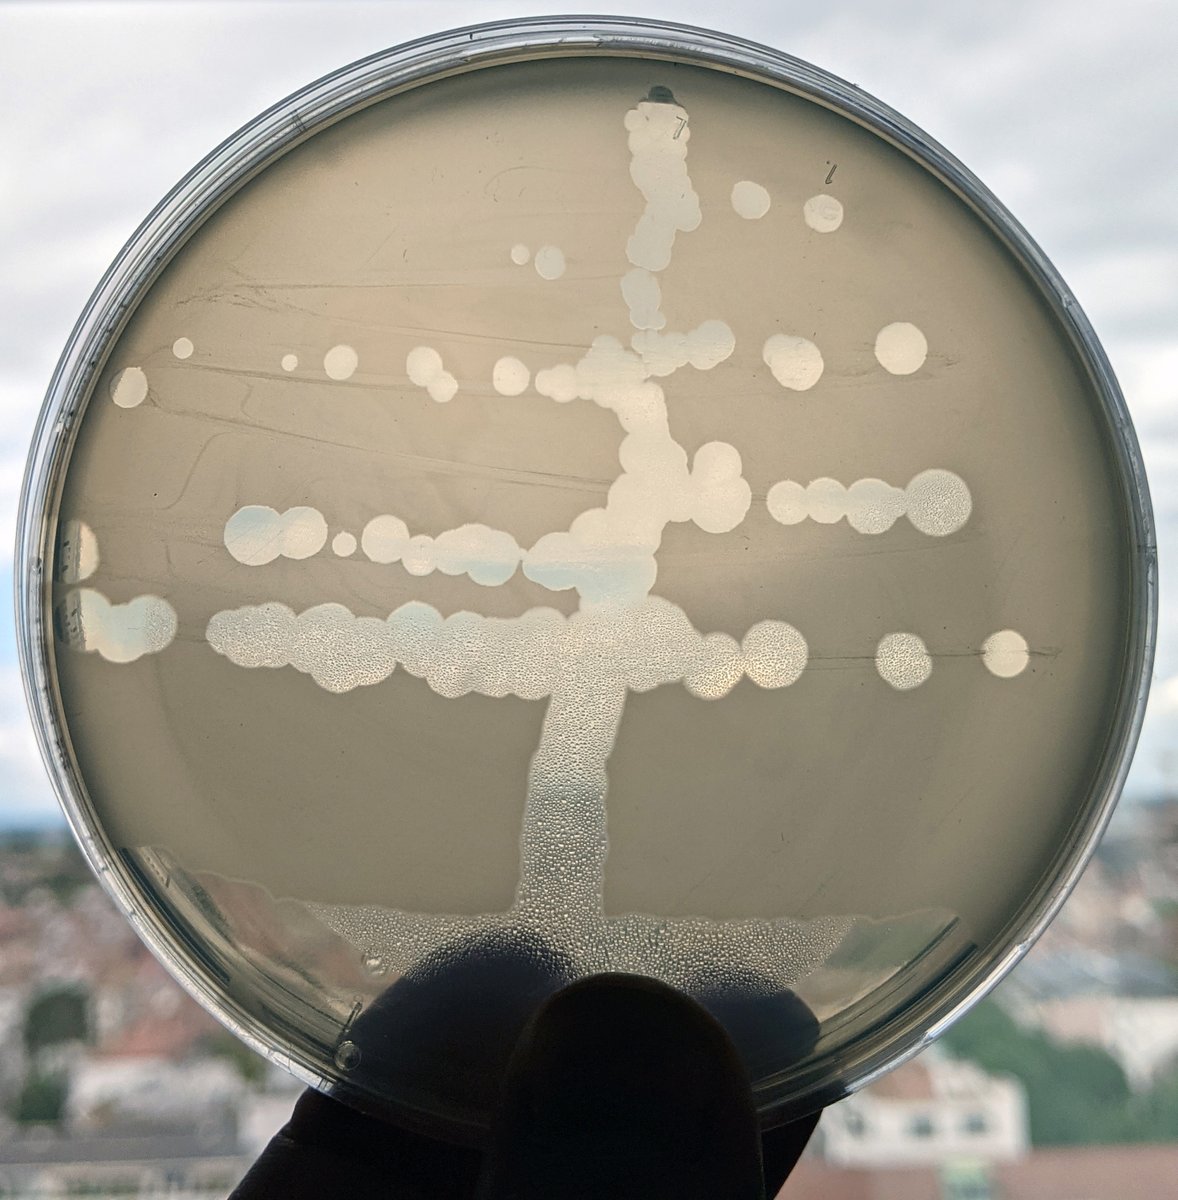

Rūta Prakapaitė
@prakapaite_r
PhD student at the @JenalLab @biozentrum 🧫👩🔬 MRes graduate @imperialcollege & BSc @VU_LT
ID: 1149233077585141760
11-07-2019 08:24:52
72 Tweet
254 Takipçi
524 Takip Edilen

Do you need a field guide on Escherichia coli phages or an assorted collection of them as a tool for genetic or evolutionary studies? Here we present the final version of our “BASEL collection” in PLOS Biology 👇😁. Short thread 1/6 journals.plos.org/plosbiology/ar…

Celebrating our first paper in Alexander Harms Phagehunters group! Wish you all many good years in science and exciting (phage😉) research🧑🔬👨🔬 journals.plos.org/plosbiology/ar…





Putin just put Kafka & Orwell to shame: no limits to dictator's imagination, no lows too low, no lies too blatant, no red lines too red to cross. What we witnessed tonight might seem surreal for democratic world. But the way we respond will define us for the generations to come.



The moment has finally come... My first (Co) first author paper is out today in The ISME Journal 🥳 and highlighted by Cambridge University news 😱🤩 We studied how polymicrobial interactions affect drug effectiveness and a new colistin resistance mechanism 🤯 👇 doi.org/10.1038/s41396…

Happy to present a product of a long standing, fun & gratifying collaboration with Adam AdamArkin_Lab. "A Phage Foundry framework to systematically develop viral countermeasures to combat antibiotic resistant bacterial pathogens" cell.com/iscience/fullt…




Preprint: We report the discovery of >20 new bacterial defense systems! Some with homology to human immune genes A 4-year effort of the entire Sorek Lab, led by talented Adi Millman, @Curiousphage, Azita Leavitt, Shany Doron and many more biorxiv.org/content/10.110…



Yesterday scientist-artist Fabienne Estermann @fabi_est_ did some bacterial agar art with our high schoolers at Biozentrum, University of Basel University of Basel! 👩🏼🎨🎨🦠🧫 I admire their creativity and precision - they would make good scientists if they want 😁.